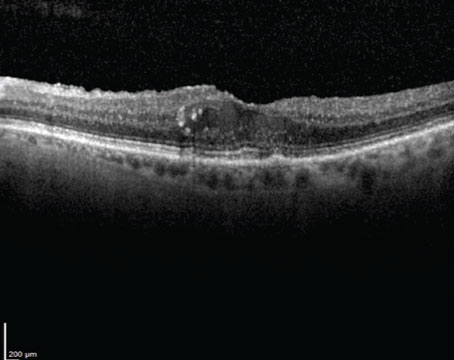

March / April 2020
Features

Gene therapy in AMD: Promises and challenges
Gene therapy could offer long-term stable control and prevent non-compliance, but the long-term effectiveness remains to be seen.

Gene therapy and editing for the retina: A primer
A look at advances in gene replacement therapy, gene delivery and CRISPR technology.
DRCR Protocol V in the real world
Here’s why we should feel more confident observing patients with center-involving diabetic macular edema with good vision.

When to operate on RVO and when to (mostly) not
The side-effect profile is significant, but a few approaches may help to extend medical treatment in selected cases.

Is drier better in neovascular AMD?
It may depend on the location of the fluid. A quick look at HARBOR post-hoc results.
Departments
Clinical Trial Closeup
Targeting a novel enzyme in GA
An investigative antibody aims to inhibit HtrA1 that contributes to progression of geographic atrophy.
Coding Commentary
New day for extended ophthalmoscopy
New rules and codes apply starting this year. The requirements are tighter and the reimbursements lower.
Editor's Page
News
North of the Border
Bringing PnR into your practice
Insights for adopting pneumatic retinopexy.
Retina CEO
How to lock in staff in a tough job market
With unemployment at an all-time low, these seven steps will help you get and keep the right people.
Retina Rounds
A Coats of many colors
A case of unilateral xanthocoria with distinct central subretinal mass.
Surgical Pearl Video
Pearls for complex diabetic TRD repair
Patience and persistence are key to relieving the tractional forces on the retina.



